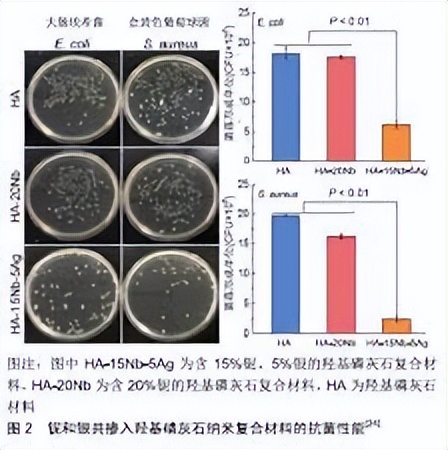
探究银离子浸渍海藻酸盐和水凝胶的制备及其抗菌性能

«——【·前言·】——»
制备海藻酸钙(CaALG)水凝胶珠和两组复合珠,由海藻酸钙/海藻酸丙二醇酯/人血清白蛋白(CaALG/PGA/HSA)的组合和由海藻酸钙与季铵盐(3-(三甲氧基甲硅烷基)丙基)-十八烷基二甲基氯化铵(QA)(CaALG/QA)形成。

牛血清白蛋白(BSA)与戊二醛(GLA)结合形成BSA/GLA水凝胶。相应的Ag+还形成了所有上述水凝胶的含凝胶,并且杀生物过渡金属离子从凝胶中的缓慢浸出赋予了广谱抗微生物活性。
在没有添加Ag的情况下+,CaALG/QA是唯一一种具有轻微至中度抗菌和抗真菌效果的材料。总检察长+浸渍水凝胶系统有可能保持银的抗菌性能,最大限度地降低毒性风险,并作为储库提供持续无菌。
«——【·介绍·】——»
在医学领域,目前对碳水化合物(如藻酸盐、壳聚糖)和蛋白质(如血清白蛋白)来源的天然水凝胶有很大兴趣,因为它们往往是无毒的、生物相容的和可生物降解的。
通过将抗微生物剂结合到聚合物基质中来增强这些生物聚合物的性能,以用于食品包装、伤口敷料和药物递送,这是目前广泛关注的问题。
随着对常规抗生素的日益增加的抗微生物抗性成为全球卫生保健问题,基于金属的络合物作为抗微生物剂的研究再次兴起。

含有生物杀灭剂银+存在于水凝胶中的离子/银纳米粒子可以提供双重功能:它们能够保持材料本身的无菌性,以及作为向目标微生物病原体缓慢、持续递送治疗性金属阳离子的储库。
Ag的强结合亲和力+已知蛋白质巯基*能官**团的离子是其非特异性、多模式抗微生物作用和微生物最终死亡的核心。

这种消毒特性,加上对哺乳动物细胞相对较高的毒性阈值,使得Ag+掺入抗微生物水凝胶的良好候选物。
戊二醛交联的牛血清白蛋白是众所周知的伤口粘合水凝胶(这里缩写为BSA/GLA ),以生物胶该产品于2001年获得美国美国食品药品监督管理局(FDA)的批准,被广泛用作外科手术中的粘合剂,如主动脉、股动脉和颈动脉修复手术。

据报道,当生物胶用于开颅手术的患者时,手术部位感染发生了增加(5.4%),当停止使用时,这恢复到1%的正常比率。
发现多种微生物是造成感染的原因,并且得出结论,BSA/GLA水凝胶粘合剂促进了炎症反应,导致随后的伤口破裂,并允许微生物向下扩散到伤口中。
当我们在实验室制备这种BSA/GLA水凝胶样品时,发现在环境温度下在大气中放置几天后,微生物生长的大量表面覆盖出现,表明该胶制剂是微生物的良好生长培养基。
这一发现促使我们探索加入抗菌活性银的可能性+以便在外科手术使用过程中保持产品和伤口部位的无菌性。

本文描述了一些已经注入Ag的藻酸盐(ALG)和BSA/GLA水凝胶的合成和抗微生物筛选+阳离子。我们报告了一种新的商业生物粘合剂(白蛋白-戊二醛)生物胶的银浸渍抗菌适应。
人们对开发和使用基于藻酸盐的含银水凝胶材料有着浓厚的研究兴趣,大量的研究调查了藻酸盐的抗微生物特性。
目前的研究是第一份关于银浸渍水凝胶的广谱抗菌性能的研究报告,该水凝胶包含化学修饰的藻酸盐水凝胶、血清白蛋白-丙二醇藻酸盐和藻酸盐-季铵复合物。

«——【·实验材料和方法·】——»
海藻酸钠,粘度为20-40厘泊,浓度为1%w/v在H2o,被用过。从Wako获得具有70%酯化作用的丙二醇藻酸酯。
微孔去离子水用于水凝胶和溶液的制备。所有在无光的情况下制备含Ag+的水凝胶,样品在黑暗中保存。

采用扫描电子显微镜(SEM)和能量色散x射线(EDX)分析对海藻酸盐水凝胶珠进行表面表征,仪器采用日立S-3200-N(英国),含钨丝电子源,最大放大倍数为300000,分辨率为3.5 nm。
该显微镜配备了牛津仪器INCAx-act EDX系统和硅漂移探测器。干燥的海藻酸盐珠(100个珠的样品)的尺寸限制使用吉利森自动筛确定。

使用奥林巴斯BX5IM显微镜测量20颗珠的直径,发现其直径范围与吉利自动筛获得的直径范围相似。
红外光谱被记录为溴化钾盘或氯化钠板之间的液体薄膜,使用Perkin Elmer系统2000 FT-IR光谱仪,然后用于量化银的浓度+从牛血清白蛋白/玻璃/银中浸出v/v一段时间内的样本。
海藻酸钙水凝胶珠+使用改编的文献程序制备CaALG水凝胶珠[+]。海藻酸钠水溶液从注射器(没有连接针头)滴加到CaCl中溶液。

氯化钙表面之间的距离溶液和注射器底部固定在60 mm,滴速保持在0.2 mL/min。
球形珠粒在磁力搅拌0.5小时下形成。新形成的珠粒(3= 500)浸泡在氯化钙中溶液,然后通过过滤除去珠子,并用去离子水反复洗涤以除去任何过量的CaCl解决方案。

这些珠子在残留去离子水的存在下储存以备后用。海藻酸钙/海藻酸丙二醇酯/人血清白蛋白复合微球(CaALG/PGA/HSA)藻酸丙二醇酯(PGA)是由氧化丙烯和藻酸反应形成的部分酯化衍生物,其中ca70%的羧基被丙二醇酯化。
将海藻酸钠(1.0克)溶解在去离子水(100毫升)中。PGA水溶液(100毫升,2% M−1)加入,随后加入人血清白蛋白(HSA)溶液(5 mL,5%)。将混合物在室温下搅拌24小时。
将所得粘性溶液(30 mL)置于注射器中,并滴加到CaCl中溶液(100毫升,10%+)。为了形成最佳的珠粒,CaCl+溶液,注射器底部固定在60 mm,滴速为0。2毫升/分钟。

由于HSA与PGA在碱性介质中反应,珠在与氢氧化钠溶液接触时立即变成白色。将珠子滤出并置于缓冲溶液(pH 7)中0.25小时。
过滤后,用去离子水反复洗涤珠子,以从表面除去任何过量的溶液。通过在残留去离子水的存在下储存,珠粒保持其水凝胶状态。

在酸性溶液中,海藻酸钠与(3-(三甲氧基甲硅烷基)丙基)-十八烷基二甲基氯化铵反应制备了含季铵基团的海藻酸盐。该反应通过不可水解的共价键将季铵基团固定在聚合物主链上。
根据Kim等人开发的方法制备CaALG/QA珠粒。将藻酸钠(4.0克)缓慢加入到搅拌的去离子水(100毫升)中,并向其中加入氯化(3-(三甲氧基甲硅烷基)丙基)-十八烷基二甲基铵(41毫升,0.02摩尔)的水溶液。
然后在室温下加入乙酸水溶液(0.8 M)以降低pH至4。混合物从淡黄色变为乳白色,并搅拌24小时。将所得粘性溶液(30 mL)放入注射器(未连接针头)中,并逐滴分配到CaCl溶液中(100毫升,约5%)。

«——【·结果和讨论·】——»
离子作为主要交联剂,在CaALG/PGA/HSA的情况下,HSA提供了额外的交联,这使珠粒具有更大的结构完整性,并为随后的Ag提供了额外的位点装订。
CaALG/QA复合珠的FTIR光谱在908和1100 cm处显示出谱带,与报道值一致,并分别归入Si-O-C和Si-O伸展。
O-CH的丢失1193厘米的拉伸带存在于季铵原料中表明SiOCH基团已经水解并且甲氧基基团丢失。珠子的EDX光谱在1.74 keV处显示一条线,该线被指定为K6α1+硅线。

这些发现与(3-(三甲氧基甲硅烷基)丙基)-十八烷基二甲基氯化铵与藻酸盐链的连接是一致的。
元素分析数据证实了氮的存在以及CaALG/QA的碳含量的增加(% C 41.69% H 7.65%N 1.62)相比CaALG(% C 21.91;%H 4.29),这与长烷基链与藻酸盐的连接相一致。

对于CaALG/QA珠粒,氯离子与硝酸根离子的交换之后是干燥珠粒的EDX光谱中氯离子信号的减少。
某些Ca的替换+含有银的各种珠子中的离子2是通过将预制的Ca-在AgNO溶液中含有珠子(0.1或0.01 M)对于CaAlG和CaALG/PGA/HSA为3小时,对于CaALG/QA为24小时。
水凝胶包括添加GLA/AgNO2+溶液到BSA的水溶液(即Ag+与用AgNO后处理凝胶相反,在水凝胶形成过程中掺入离子−1如藻酸盐水凝胶珠的情况)。

应该注意的是,如果Ag太多3离子用于BSA/GLA/Ag的合成−1(例如,使用0.1 M AgNO3),形成非粘性糊状物而不是水凝胶。
添加的Ag太少BSA/GLA/Ag期间的离子) 水凝胶形成产生缺乏有效抗菌保护的凝胶。
−1当生物聚合物材料处于干凝胶形式时,记录它们的表面形态。对于各种类型的海藻酸钙珠,含有添加的银的珠的形态BSA/GLA/Ag期间的离子离子与不含Ag的前体珠非常相似。

在用Ag浸渍后,没有观察到藻酸盐珠的尺寸的显著变化离子;例如,CaALG和CaALG/Ag两种珠子的中值直径都在600-710m范围内(通过筛分实验确定)。
复合珠(+c,d)基本上不太对称,这可能是由于用于胶凝过程的聚合物溶液的粘度增加,并且它们的表面显示出大的褶皱。
CaALG/QA/Ag3(0.1)含有季铵*能官**团的珠粒具有非常粒状的形态。

不含金属的BSA/GLA复合材料的表面(+a)看起来光滑,虽然它是非常不均匀的,包含直径约的深坑。干燥样品中后面的凹痕可能是渗透到前面水凝胶中的充满水的大孔的残余物。
BSA/GLA/Ag+(0.01)样品也具有非常光滑的表面,但是没有凹坑压痕,这可能反映了孔隙率的降低和由于驻留Ag的交联而产生的更紧密的基体+离子。

在8小时的研究中,三组珠子在去离子水中的质量增加了相似的量。相反,CaALG/PGA/HSA和CaALG/QA的溶胀程度比1%的CaALG珠小得多+氯化钠溶液。
当从去离子水溶液到1%时,CaALG/QA溶胀仅略微增加+NaCl,表明这种材料受Na的损害不太严重阳离子。
这些阳离子在血液中的含量约为0。8%。这些阳离子在血液中的含量约为0。8%去离子水中藻酸盐基珠的ESD%和1%36NaCl在20±1°C温度下保持8小时+吸收和释放银的数据。

水凝胶加入到水性纳米+使用溶出伏安法在55小时内的多个时间点记录室温下的支持电解质。对于这两个样品,银的浸出相对较快+在第一个小时内,材料中的离子进入支持电解质。
Ag的增加不太明显然后离子释放变慢,大约24 h似乎达到平衡浓度值。在这个时间点。原始Ag的35%和38%+BSA/GLA/Ag含量+(0。001)分别被释放到支持电解质溶液中。
Ag的范围+BSA/GLA水凝胶的离子浸出与Babu等人报道的结果没有太大的不同。[+]对于基于聚乙二醇或乳糖主链的3,4-二羟基苯基-+-丙氨酸聚合物凝胶(24小时后分别为57%和44%)。
银的浓度+离子释放到0.2 M纳米的水溶液中+使用电化学测定从BSA/GLA/Ag获得的支持电解质+(0.01)水凝胶圆盘超过55小时。
根据沉积时间和Ag对剥离峰电流进行归一化+(0.1),分别对应于Ag量的5.6%和2.2%+使用平均标准化校准曲线参数确定的浓度。
藻酸盐和BSA/GLA样品的抗微生物活性使用平板法并通过在37℃下培养24小时后测量微生物生长抑制区来评估。

当用没有添加Ag的CaALG、CaALG/PGA/HSA和BSA/GLA水凝胶攻击生物体时,没有观察到生长抑制作用+离子。
相反,如Kim等人先前观察到的,CaALG/QA珠,其含有季铵基团但不含Ag+从BSA/GLA/Ag中浸出的离子+离子显示出广谱抗微生物活性,但对革兰氏阳性菌的活性高于革兰氏阴性菌。

已知含有季铵盐的消毒剂对许多细菌种类具有很强的毒性,这种作用被认为是通过阳离子铵部分与细菌外表面阴离子位置的结合来介导的。
抗菌生长抑制区(毫米含凝胶的样品显示出一定程度的微生物生长抑制。

对于三组藻酸盐配对,通常发现使用较高浓度的AgNO制备的样品+显示出对大多数(但不是全部)微生物的优异活性。
这种趋势可能是由于银的含量增加+从BSA/GLA/Ag中浸出的离子+根据沥滤研究预测的扩散到周围介质中的离子,与兰斯多恩报告的结果一致,卡斯特利亚诺等人也是如此,他们研究了八种市售Ag的抗菌活性l-包含伤口敷料。

相比之下,两个BSA/GLA/Ag样品仅在与真菌直接接触的点抑制生长,这意味着在这些情况下,没有Ag的扩散总的来说,援助小组水凝胶表现出中等至良好的抗菌活性,在革兰氏阳性菌和革兰氏阴性菌之间没有任何明显的偏见,尽管这两类细菌的细胞壁组成非常不同。
银的制备+27,853。CaALG/Ag3对革兰氏阳性菌的高度有害作用是无可匹敌的+抗甲氧西林金黄色葡萄球菌17。

在伤口敷料中使用藻酸盐水凝胶的一个严重问题是水凝胶在溶胀时的低稳定性,这是在失去三维网络时发生的。
这可能导致水凝胶中捕获的生物活性物质的突然释放。改性海藻酸盐珠具有更吸引人的特征;与1%的CaALG珠粒相比,它们表现出降低的吸水性能+氯化钠溶液。

当珠被置于用于培养微生物的营养溶液中并在30℃下摇动24小时,观察到6小时后,银离子浸渍的CaALG珠已经分解,而类似的CaALG/QA CaALG/PGA/HSA珠,即使极大地溶胀,在24小时时间标记时仍然是完整的。+4。结论+(0.01)。
«——【·结论·】——»
我们已经证明了Ag3含β的功能化藻酸盐和BSA/GLA水凝胶易于使用廉价、易得的原料制备,并对多种微生物病原体具有良好的生长抑制作用。
含有侧季铵(QA)基团的藻酸盐在没有添加银的情况下具有生物活性图S6离子;Ag的加入+显著增强了这种活性。

与CaALG珠相比,CaALG/PGA/HSA和CaALG/QA在水和盐水溶液中显示出降低的溶胀,因此具有作为掺入生物活性剂的伤口敷料应用的更大潜力。
关于它们在临床中的*在用潜**途,作为皮肤伤口防腐基质或富含防腐剂的组织粘合剂,藻酸盐和BSA/GLA Ag2含银凝胶通过缓慢持续释放抗菌银发挥微动效应(在极低浓度下具有生物活性)+离子,有效减轻生物负担。

«——【·引用·】——»
1、麦肯,杰拉蒂,德弗罗,梅森,奥沙利文:《洞察反垄断法的行动模式假丝酵母》, 2018年,哈佛大学出版社。
2、卡瓦纳格,麦肯,德弗罗:《菲咯啉及其铜(II)、锰(II)和银(I)络合物的抗真菌活性模式》,2020年,斯坦福大学出版社。
3、罗万河,麦肯:《暴露于卡泊芬净激活Cap和Hog通路》, 2020年,剑桥大学出版社。